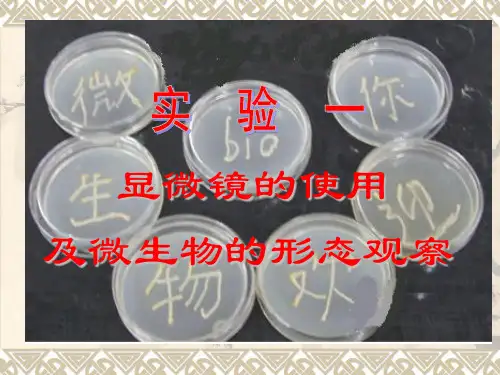

生物显微镜的使用及显微绘图
- 格式:docx
- 大小:171.82 KB
- 文档页数:3






实验一显微镜的使用及生物绘图法一、实验目的:了解一般光学显微镜的构造,初步掌握显微镜的使用方法。
掌握生物学绘图的基本方法。
二、实验内容:观察显微镜的基本构造,了解显微镜的基本性能。
通过对永久装片的观察,学习使用显微镜的方法。
学会并使用生物绘图法绘制生物图。
三、材料与用具:复式光学显微镜、杨树三年茎永久装片、椴树二年茎永久装片、玉米茎横切、水稻茎横切、铅笔(2H、HB各一只)、绘图橡皮、直尺、绘图纸。
四、操作及观察:(一) 显微镜的使用方法:1.安放镜座:用右手握镜臂,左手托镜座,将显微镜放置在自己身体的左前方,镜筒向前,镜臂向后。
2.对光:使用低倍物镜对准通光孔,调节反射镜,在目镜中能看见大片白色视野为佳。
3.低倍镜的使用:将永久装片放置于载物台上,将标本与通光孔重合,转动粗准焦螺旋,使镜筒下降到一定高度,在目镜中可见一模糊实像,继续使用粗准焦螺旋调节镜筒高度,使目镜中的像清晰可辨。
4.高倍镜的使用:在低倍镜中观察不清,分辨不明的可以在高倍镜中观察。
将要观察的部位调节至视野正中,转动镜头转换器,换成高倍镜,转动细准焦螺旋,使目镜中的像清晰。
高倍镜的视野小,光线暗,观察时可以适当调节进光量,使视野清晰。
(二) 使用显微镜的注意事项:1.取用显微镜时必须使用左手握镜臂,右手托镜座,以免碰撞及目镜脱落。
2.放置显微镜时要轻,防止剧烈震动。
3.目镜、物镜上落有灰尘时严禁用手指擦拭,防止汗水污损镜头。
镜头有专用的擦镜纸擦拭,严禁使用其他纸张与手帕擦拭。
4.放置装片时,应将有盖玻片的一面向上,否则会压坏标本或物镜。
5.严禁自行拆卸显微镜,防止零件丢失及损坏。
6.调节准焦螺旋时要慢、轻,防止损坏齿轮。
7.观察时双眼都要睁开,左眼观察,左手调节,右眼右手用于绘图和调整标本。
8.实验完毕后必须取出装片,降下镜筒,使物镜轻触载物台,盖上防尘罩,放入镜箱。
(三) 生物绘图法:1.作图前先了解本次作图的要求,确定好各图之间的比例,如本次实验要作两幅图,那么每个图就占一幅绘图纸的一半,即合理分配纸张大小,不可只在一侧作图。

实验一显微镜的构造、使用及生物绘图方法
目的和要求
1、掌握显微镜的构造及原理,熟练使用光学显微镜。
2、了解显微镜使用的基本要求、注意事项及一般维护方法。
3、学习生物绘图的基本要求及方法。
实验内容
认识显微镜的结构,练习低倍镜、高倍镜的使用。
教学方法
教师讲解并演示显微镜的使用过程,学生自己练习使用,教师检查并个别辅导。
主要仪器设备和试剂
显微镜、载玻片、盖玻片、解剖针、镊子和解剖刀。
操作步骤
1.光学显微镜的构造
光学部分:物镜、目镜、聚光器和反光镜等。
机械部分:镜座、镜臂、载物台、镜筒、物镜转换器、粗细调节螺旋等
2.显微镜的使用步骤
(1)放置放在左胸前,离桌边5cm的位置.
(2)对光用低倍镜,开大光圈,转动反光镜使视野充分明亮,光线均匀。
(3)低倍镜使用放好制片,从侧面观察降低镜筒至距制片0.5cm,通过目镜观察,逐渐上升镜筒至看见清物象。
(4)高倍镜使用在低倍镜下找到要观察的目标,移到视野中央,换高倍镜,转动细调节螺旋使影像清晰。
(5)收镜
(6)维护保持清洁,光学部分可用擦净纸沾清洁液清洁。
机械部分用干净的软布清洁。
思考题
1.显微镜使用过程中应注意的事项由哪些?
2.如何保养和维护显微镜?。

第5章显微镜专门实验5.1 生物显微镜的使用及显微绘图生物显微镜是用来观察生物切片、生物细胞、细菌以及活体组织培养、流质沉淀等的观察和研究,同时可以观察其他透明或者半透明物体以及粉末、细小颗粒等物体。
【实验目的】(1)了解显微镜的结构和各部件性能。
(2)熟悉低倍镜、高倍镜的正确使用方法。
(3)熟悉生物显微绘图的基本方法。
(4)掌握仔细阅读显微镜使用说明书并进行正确操作的方法。
【实验原理】生物显微镜的光学成象系统由两部分组成,靠近物体部分的透镜组称为物镜,靠近眼睛的透镜称为目镜。
物镜组使物体在目镜的前焦面内形成一个放大而倒立的实象(也称中间象),经目镜再成象在明视距离250毫米处,供眼睛观察。
因此,显微镜是一个二次成象系统,其成象光路如图5-1-1所示。
图5-1-1 生物显微镜的光路图【实验器材】FM-179B型生物显微镜、生物切片(人体、动物、植物组织切片)、电子目镜FM-179B型生物显微镜的外形结构图如图5-1-2所示。
图5-1-2FM-179B型生物显微镜外形结构图【实验内容与步骤】实验室提供FM-179B型生物显微镜的使用说明书,仔细阅读说明书,并对照显微镜实物,学习如何使用显微镜。
一、物镜的使用1.打开显微镜电源开关,调节调光转轮,光线应逐步增强。
转动粗动调焦手轮,将载物台下降,使物镜与载物台距离略拉开。
再旋转物镜转换器,将低倍镜4 X对准载物台中央的通光孔。
2.放标本切片:标本切片标签面向上,用标本夹夹好,把要观察的部分移到通孔的正中央。
3.调节焦距:调节粗动调焦手轮,使载物台缓慢上升,直至视野中出现物像为止。
如物像不太清晰,可转动微动调焦手轮,使物像更加清晰。
4.换10X 、40X物镜观察。
此时,只须稍稍调节微动调焦手轮即可,适当调大光源强度和孔径光栏。
二、生物显微绘图---画图表示在显微镜下观察到的生物切片形态生物显微绘图不同于一般的美术绘图,要求将所观察切片的外形和内部结构准确地描绘,然后对各部分分别加以注字说明。


显微镜的使用、徒手切片法及绘图法一.实验目的⑴掌握徒手切片、表面制片方法⑵熟悉显微镜使用方法及作图要领二.实验内容1.显微镜的使用生物显微镜由光学部分和机械部分组成⑴光学部分——目镜、物镜、聚光器、可变光栏、反射镜※两次放大,即物镜将标本做第一次放大,目镜将第一次放大的像做第二次放大,两者相乘即是观察到的放大倍数⑵机械部分包括镜坐、镜臂、镜筒、载物台、粗细调节手轮及推动器⑶操作:①将显微镜防置离桌缘约10厘米处②对光:上升聚光镜至载物台水平,打开光栏,将低倍镜转至镜筒的正下放(用转盘听到“得”一声)转动反光镜,同时从接目镜向下看,直至明亮均匀在视野。
③装片:将观察的标本片从镜前方横置于载物台上④调节焦距:向外旋转粗调节手轮,使镜筒慢慢下降,注意镜头与标本的距离,自目镜向下观察直至物像清楚为止。
(向外物镜下降,向内物镜上升)另外:高倍镜应先在低倍镜下选择物像,移至视野中心,转动转盘使高倍镜转至镜筒正下方,应能看到欲观察之物像,用细调节手轮使之图象清晰。
⑷注意点:①取拿显微镜时,一手握镜臂,一手托镜坐,轻取轻放。
②先用低倍镜观察,看清物象后再换高倍镜,③在用高倍镜观察时,注意物镜与所观察标本的间距,以防错误操作,而损坏镜头,压碎标本片④注意保持显微镜的干燥和清洁,不得随意拆卸镜头,镜头要用擦镜纸擦拂,要防止水或药液外溢而污染镜头及其他部位。
2.徒手切片法系用刀片或徒手切片器将材料切成薄片,可在显微镜下观察组织构造、细胞特征的制片法。
材料:新鲜应除净泥沙、干燥须经软化,优点:简便快速能保持植物原有结构的真像,色彩和内含物缺点:厚薄不一,不利于长期保存。
①方法a:取材,固定与切片:选取易软化的中药材适当部位,切成2-3厘米的小段,用拇指及食指和中指夹住材料,下端用无名指托住,另手持刀片自左向右移动手腕,牵拽切片,动作要轻要快,切禁不能是拉锯式,在切的同时经常用水湿润,对于叶或柔软的材料,须用材料夹住。
(如用胡萝卜、马铃薯等)b:装片:将切好的薄片用毛笔小心移入盛有清水的培养皿中,取载玻片滴加甘油和试液,用镊子或毛笔将切片移于其上。
附录《显微镜的使用》1、取送显微镜时,应右手握住镜臂,左手托住镜座,轻拿轻放。
切勿用一只手斜提,前后摆动,防止目镜滑出跌落。
使用时,显微镜应放在距实验台边缘7厘米左右处,略偏左。
2、保护好镜头,揩试目镜、物镜上的灰尘或污物,必须使用专用的擦镜纸。
切勿用手指、手帕、纱布和普通纸擦。
3、物镜镜头的切换一定要使用转换器,以免使镜头脱落和损坏。
4、转动粗、细准焦螺旋时,不要用力过猛,以防止机件损伤,调节失灵。
5、镜检时,坐姿端正,一般用左眼观察物象,用右眼看着实验报告纸画图。
两眼须同时睁开,以减少疲劳。
6、切忌一面从目镜进行观察,一面使镜筒下降,这样容易使物镜与玻片标本碰撞而损坏。
7、载物台要保持清洁干燥。
如使用新鲜材料做临时装片,必须在载玻片上加盖盖玻片。
切勿让材料、水滴、试剂接触物镜和载物台。
如沾上,应立即揩擦干净,以免镜头等被污染和腐蚀。
8、在高倍镜下调节焦距时,切勿使用粗调节器,以免压坏标本,损坏物镜。
9、高倍镜使用完毕,必须先上升镜筒,移开镜头后再取出玻片标本,以免取玻片时擦损镜头的镜面。
10、绝对禁止随意取出目镜或拆下显微镜的其他部件,以免灰尘掉入镜筒、部件失落或损坏。
附录《生物图的画法和注意事项》1、图的大小要适当,在纸上的位置要适中。
一般稍偏左上方,以便在右侧和下方留出注字和写图名的地方。
2、先用削尖的铅笔,根据观察到的物像(不能抄书),轻轻地画出轮廓,经过修改,再正式画好。
务必使图形真实。
3、图中比较暗的地方,用铅笔点上细点来表示(越暗的地方,细点越密集。
不能以涂阴影表示暗处)4、字尽量注在图的右侧。
用尺引出水平的指示线,然后注字。
5、在图的下方写上所画图形的名称,并标注物像的放大倍数。
第5章显微镜专门实验
5.1 生物显微镜的使用及显微绘图
生物显微镜是用来观察生物切片、生物细胞、细菌以及活体组织培养、流质沉淀等的观察和研究,同时可以观察其他透明或者半透明物体以及粉末、细小颗粒等物体。
【实验目的】
(1)了解显微镜的结构和各部件性能。
(2)熟悉低倍镜、高倍镜的正确使用方法。
(3)熟悉生物显微绘图的基本方法。
(4)掌握仔细阅读显微镜使用说明书并进行正确操作的方法。
【实验原理】
生物显微镜的光学成象系统由两部分组成,靠近物体部分的透镜组称为物镜,靠近眼睛的透镜称为目镜。
物镜组使物体在目镜的前焦面内形成一个放大而倒立的实象(也称中间象),经目镜再成象在明视距离250毫米处,供眼睛观察。
因此,显微镜是一个二次成象系统,其成象光路如图5-1-1所示。
图5-1-1 生物显微镜的光路图
【实验器材】
FM-179B型生物显微镜、生物切片(人体、动物、植物组织切片)、电子目镜
FM-179B型生物显微镜的外形结构图如图5-1-2所示。
图5-1-2FM-179B型生物显微镜外形结构图
【实验内容与步骤】
实验室提供FM-179B型生物显微镜的使用说明书,仔细阅读说明书,并对照显微镜实物,学习如何使用显微镜。
一、物镜的使用
1.打开显微镜电源开关,调节调光转轮,光线应逐步增强。
转动粗动调焦手轮,将载物台
下降,使物镜与载物台距离略拉开。
再旋转物镜转换器,将低倍镜4 X对准载物台中央的通光孔。
2.放标本切片:标本切片标签面向上,用标本夹夹好,把要观察的部分移到通孔的正中央。
3.调节焦距:调节粗动调焦手轮,使载物台缓慢上升,直至视野中出现物像为止。
如物像
不太清晰,可转动微动调焦手轮,使物像更加清晰。
4.换10X 、40X物镜观察。
此时,只须稍稍调节微动调焦手轮即可,适当调大光源强度和
孔径光栏。
二、生物显微绘图---画图表示在显微镜下观察到的生物切片形态
生物显微绘图不同于一般的美术绘图,要求将所观察切片的外形和内部结构准确地描绘,然后对各部分分别加以注字说明。
生物显微绘图应注意科学性和准确性;点、线要清晰流畅,线条要出,粗细均匀,光滑清晰,接头处无分叉和重线条痕迹,切忌重复描绘;一般用圆点衬阴,表示明暗和颜色的深浅,给予立体
感;点要圆而整齐,大小均匀,根据需要灵活掌握疏密变化,不能用涂抹阴影的方法代替圆点;比例要正确;写明图题。
本实验配有电子目镜。
换上电子目镜,连接电脑,调节微动调焦手轮,在电脑上就可以得到清晰的显微图像。
【数据记录与处理】
生物切片进行镜检后,观察结果,并进行绘图记录。
自学提纲
1. 实验室提供显微镜使用说明书,仔细阅读说明书,简述使用显微镜的注意事项。
2. 如何判断视野中所见到的污点来源?显微镜下看到的物像是正像还是反像?物像与载玻片的移动方向是否一致?
3.什么是生物显微绘图?绘图时需要注意什么?。